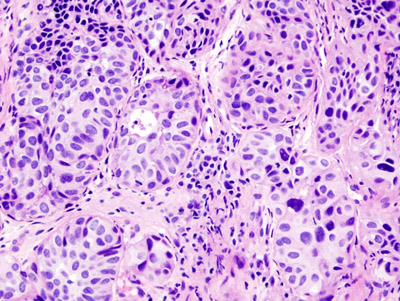
Urothelial Carcinoma

Kidney and Bladder Neoplasia Pathology Video
Kidney and bladder neoplasia includes:
- Angiomyolipoma
- Renal cell carcinoma
- Wilms tumor
- Urothelial carcinoma
- Squamous cell carcinoma of the bladder
- Adenocarcinoma of the bladder
Angiomyolipoma
Angiomyolipoma is a disorder where benign kidney tumors develop.
Angiomyolipoma a tumor made up of blood vessels, smooth muscle, and adipose tissue.
Tuberous sclerosis is associated with angiomyolipoma.
Renal Cell Carcinoma (RCC)
Renal cell carcinoma (RCC) is a malignant cancer cells are located in the lining of kidney tubules, which are incredibly tiny tubes. This condition is known as renal cell carcinoma.
Symptoms of renal cell carcinoma include:
- Hematuria (most common)
- Palpable mass
- Flank pain
- Fever
- Weight loss
- Paraneoplastic issues
Rarely, renal cell carcinoma may present with a left-sided varicocele.
The left spermatic vein cannot drain properly due to cancer in the left renal vein, which causes a varicocele.
Right-sided varicocele is not seen because the right spermatic vein empties straight into the inferior vena cava (IVC).
When examined under a microscope, the most common variant of renal cell carcinoma shows clear cytoplasm or a clear cell type.
Loss of the tumor suppressor gene VHL causes an increase in the growth-promoting hormone IGF-1 and the transcription factor HIF, which in turn causes an increase in the growth hormones VEGF and PDGF.
Renal cell carcinomas (RCCs) may be hereditary or sporadic.
Risk factors for sporadic renal cell carcinoma (RCC) includes:
- Male
- Age of 60 or older
- Smoking
Hereditary renal cell carcinomas (RCCs) typically develop in younger adults and are bilateral.
The autosomal dominant illness known as von Hippel-Lindau disease increases the risk of renal cell carcinoma (RCC) and cerebellar hemangioblastoma by inactivating the VHL gene.
Wilms Tumor
Wilms tumor is a malignant kidney tumor composed of primitive glomeruli, tubules, and stromal cells blastema which is an immature kidney mesenchyme.
The average age of a child who develops a Wilms tumor is 3-years-old.
Symptoms of Wilms tumor include:
- Large mass
- Unilateral flank mass
- Hematuria
- Hypertension brought on by renin secretion
Wilms tumor is associated with WT1 mutation, especially in syndromic cases.
WAGR syndrome is the disease called for its features, which include:
- Wilms tumor
- Aniridia
- Genitourinary abnormalities
- Intellectual impairment
Beckwith-Wiedemann syndrome is another disease associated with Wilms tumor, and includes:
- Wilms tumor
- Neonatal hypoglycemia
- Muscular hemihypertrophy
- Organomegaly
Urothelial Carcinoma
Urothelial carcinoma is also known as transitional cell carcinoma.
The epithelial lining of the renal pelvis, ureter, bladder, or urethra is the source of this malignant tumor.
Urothelial carcinoma is the most typical type of bladder cancer.
Risk factors for urothelial carcinoma include:
- Cigarette smoke (major risk factor)
- Naphthylamine
- Azo dyes
- Cyclophosphamide
- Phenacetin
The typical presentation of urothelial carcinoma is painless hematuria in an adult.
Urothelial carcinoma arises via two distinct pathways:
- Flat
- Papillary
Flat urothelial carcinoma is characterized by the invasion of a high-grade flat tumor and is associated with p53 early mutations.
Papillary urothelial carcinoma initially appears as a low-grade papillary tumor, advances to a high-grade papillary tumor, then invades, and is not linked to early p53 mutations.
A field defect is when a tumor recurs and is frequently multifocal in nature.
Squamous Cell Carcinoma of the Bladder
The second most prevalent type of bladder cancer is squamous cell carcinoma (SCC) of the bladder.
Squamous cell carcinoma (SCC) of the bladder is characterized by abnormal, accelerated squamous cell proliferation.
The normal bladder surface is not coated with squamous epithelium, hence this cancer develops against a backdrop of squamous metaplasia.
Symptoms of squamous cell carcinoma (SCC) of the bladder include:
- Chronic cystitis in older women
- Infection with Schistosoma haematobium in Egyptian males
- Persistent nephrolithiasis
Adenocarcinoma of the Bladder
Adenocarcinoma of the bladder is a type of bladder cancer due to malignant glandular cells.
Adenocarcinoma of the bladder may arise from:
- Cystitis glandularis
- Exstrophy
Cystitis glandularis is associated with a urachal remnant and causes adenocarcinoma of the bladder that develops near the dome of the bladder.
Exstrophy is a congenital failure to form the caudal portion of the anterior abdominal and bladder walls.